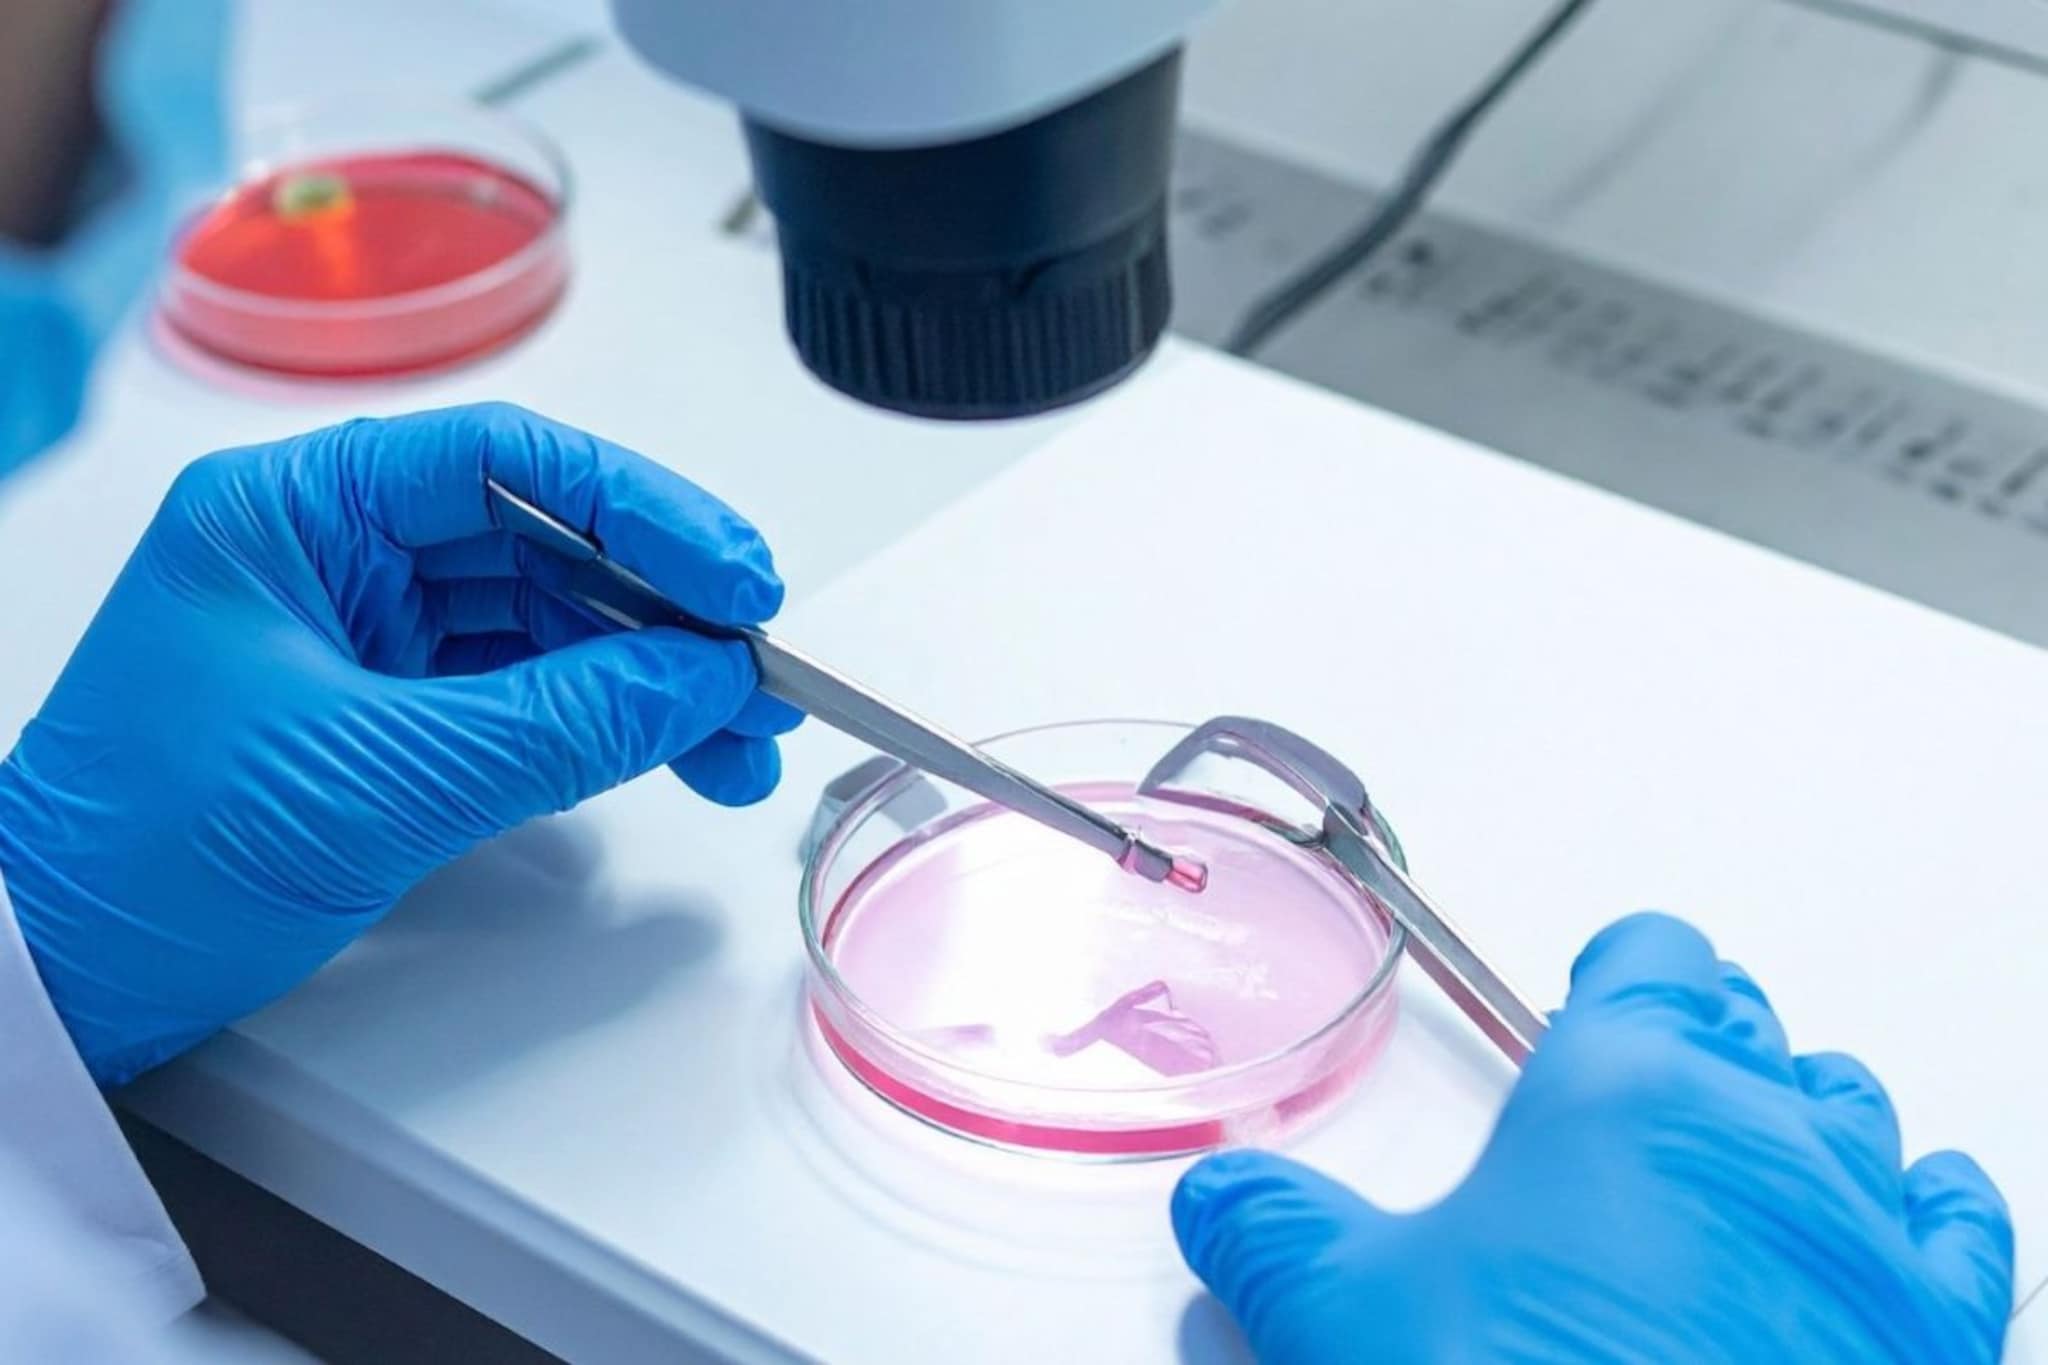
पुरुषांच्या शरीरात 'स्पर्म' कसे तयार होतात? किती काळ राहतात जिवंत?

भारतीय बँकिंग क्षेत्रात खळबळ, 45 वर्ष जुनी बँक विक्रीला; 22 हजार कर्मचाऱ्यांच्या नोकऱ्या धोक्यात
- Published by:Jaykrishna Nair
Last Updated:
जर्मनीच्या दिग्गज Deutsche Bank ने भारतातील आपला संपूर्ण रिटेल बँकिंग व्यवसायाची विक्री करण्याचे ठरवले असून यामुळे बँकिंग क्षेत्रात मोठी खळबळ उडाली आहे. या निर्णयामुळे 22 हजारांहून अधिक कर्मचाऱ्यांचे भविष्य धोक्यात येण्याची शक्यता वर्तवली जात आहे.
मुंबई: जर्मनीच्या डॉइश बँकेने (Deutsche Bank) भारतातील आपला रिटेल बँकिंग व्यवसाय पूर्णपणे विकण्याचा निर्णय घेतला आहे. यासंदर्भात रॉयटर्स वृत्तसंस्थेने एक अहवाल प्रकाशित केला आहे. ज्यात म्हटले आहे की बँकेने भारतातील आणि परदेशी बँकांना यासाठी बोली लावण्याचे आमंत्रण दिले आहे. हा निर्णय बँकेच्या जर्मनीबाहेरील सर्वात मोठ्या ऑपरेशन बेसवर परिणाम करणार आहे. जिथे सुमारे 22,000 कर्मचारी काम करतात.
advertisement
भारतातील बँकेचा प्रवास
डॉइश बँकेने 1980 च्या दशकाच्या सुरुवातीला भारतात आपला व्यवसाय सुरू केला. सुरुवातीपासूनच बँकेने केवळ रिटेल बँकिंगपुरते मर्यादित न राहता, कॉर्पोरेट बँकिंग, ट्रेझरी, डेरिवेटिव्हज, प्रायव्हेट वेल्थ मॅनेजमेंट आणि इन्व्हेस्टमेंट बँकिंग अशा विविध सेवाही दिल्या. सध्या देशभरात तिच्या 17 रिटेल शाखा आहेत. मार्च 2025 पर्यंत बँकेने केवळ रिटेल व्यवसायातून 278.3 दशलक्ष डॉलर्सचा महसूल मिळवला होता. तर संपूर्ण भारतीय व्यवसायातून तिचा निव्वळ महसूल 1 अब्ज डॉलर्स होता.
advertisement
व्यवसाय विक्रीचे कारण
हा निर्णय अचानक घेण्यात आलेला नाही. डॉइश बँकेचे सीईओ क्रिश्चियन सेव्हिंग यांनी 2025 मध्ये जगभरात 2000 नोकऱ्या कमी करण्याची आणि शाखांची संख्या मोठ्या प्रमाणात घटवण्याची घोषणा केली होती. हा निर्णय त्याच मोठ्या जागतिक धोरणाचा एक भाग मानला जात आहे.
advertisement
शिवाय Citi आणि Standard Chartered सारख्या इतर मोठ्या परदेशी बँकांनीही अलीकडच्या काळात भारतातून आपला रिटेल व्यवसाय विकला आहे किंवा कमी केला आहे. भारत हा एक वेगाने वाढणारा बाजारपेठ असला. तरी परदेशी बँकांना येथे स्थानिक बँकांकडून तीव्र स्पर्धा आणि नियामक नियमांचे पालन करताना अनेक अडचणींचा सामना करावा लागतो.
advertisement
रॉयटर्सच्या अहवालानुसार बँकेने 29 ऑगस्टपर्यंत बोली मागवल्या होत्या. परंतु संभाव्य खरेदीदारांची नावे किंवा या व्यवहाराचे एकूण मूल्य याबाबत अद्याप कोणतीही माहिती उपलब्ध नाही. बँकेच्या या निर्णयांमुळे भारतातील 22,000 हून अधिक कर्मचाऱ्यांच्या भवितव्यावर प्रश्नचिन्ह निर्माण झाले आहे.
Location :
Mumbai,Maharashtra
First Published :
Sep 01, 2025 7:57 PM IST
मराठी बातम्या/मनी/
भारतीय बँकिंग क्षेत्रात खळबळ, 45 वर्ष जुनी बँक विक्रीला; 22 हजार कर्मचाऱ्यांच्या नोकऱ्या धोक्यात